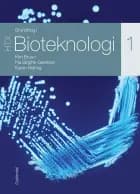
Grundbog i bioteknologi 1 - HTX af Kim Bruun, Pia Birgitte Geertsen og Karen Helmig

| Netboghandler | Pris | Fragt | Pris inkl. fragt |
|---|---|---|---|
| ComputerSalg.dk | 545,00 | 39,00 | |
| williamdam.dk | 557,00 | 35,00 | |
| iMusic.dk | 578,00 | 35,00 | |
| Bog&ide | 659,95 | 0,00 | |
| Gucca | 639,95 | 39,95 |
Grundbog i bioteknologi 1 - HTX
af Kim Bruun, Pia Birgitte Geertsen, & Karen Helmig
Hæftet bog, 280 sider
ISBN: 9788702251432
Udgivet 16-04-2018 af Forlaget Systime
Vi er stødt på 1 anmeldelse af bogen "Grundbog i bioteknologi 1 - HTX" i de 527 aviser, blogs og andre medier, vi følger. Find citater, links og korte uddrag herunder.